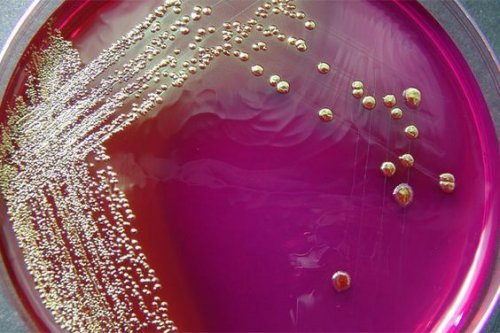
Lo studio per migliorare la diagnosi di mastite ha lo scopo di individuare a quale ceppo appartiene il batterio responsabile dell'infezione

Uno studio microbiologico per migliorare la diagnosi di mastite

Uno studio microbiologico per migliorare la diagnosi di mastite. È questo il progetto realizzato da alcuni specialisti del Dipartimento di nutrizione, bromatologia e tecnologia degli alimenti dell’Universidad Complutense di Madrid.
La mastite è un processo infiammatorio a carico della mammella che colpisce una donna su dieci nelle prime due settimane di allattamento dopo il parto. In genere, questa condizione si cura in maniera efficace con gli antibiotici. Ma può capitare che i batteri si rivelino resistenti ai farmaci.
Il progetto è stato presentato durante l’XI Simposio Internazionale sull’Allattamento al seno e la lattazione. Si pone come obiettivo quello di migliorare la diagnosi della mastite per mezzo di una valutazione delle caratteristiche dei batteri coinvolti in ogni caso. Secondo gli esperti, infatti, le probabilità di successo di ogni cura possono variare se prima si esegue un’analisi microbiologica della malattia.
Perché è utile migliorare la diagnosi di mastite?
Se si estende il periodo di comparsa della malattia oltre le due settimane, i casi di mastite possono arrivare a colpire fino al 95% delle madri che allattano. Ciò significa che la maggior parte delle donne in fase di allattamento potrebbero sviluppare questa infezione prima del primo mese del processo.
In alcuni casi l’infezione potrebbe peggiorare o, non dare alcun segno di risposta positiva alla cura. Ciò avviene perché i batteri sono resistenti agli antibiotici prescritti. Secondo Juan Miguel Rodríguez, il medico che ha condotto la ricerca, i batteri coinvolti nel 50% dei casi di mastite presi in esame, si sono rivelati resistenti alla cura.

Per i casi di mastite è frequente la prescrizione di antibiotici come l’eritromicina e l’amoxicillina. Tuttavia, in oltre la metà dei casi l’organismo non reagisce alle cure come dovrebbe.
Per questo motivi, gli esperti dell’Universidad Complutense di Madrid hanno effettuato questa importante ricerca che consente loro di affermare che la situazione potrebbe migliorare se si eseguisse un antibiogramma e una coltivazione di latte materno.
L’analisi proposta, oltre a migliorare la diagnosi di mastite rendendola molto più specifica, serve a offrire alla paziente una cura più mirata. Per individuare la resistenza di un determinato batterio a un certo gruppo di antibiotici, conviene prima eseguire un antibiogramma.
In questo modo la madre evita l’assunzione di troppi farmaci che a volte può provocare la sospensione dell’allattamento materno, tanto importante invece per il bambino.
Gli effetti dello studio
Secondo gli studi, la mastite è provocata soprattutto da due gruppi di batteri: lo streptococco e lo stafiloccco. Quest’ultimo ha un’incidenza di almeno il 75% dei quattromila casi analizzati dagli esperti del Dipartimento di nutrizione, bromatologia e tecnologia degli alimenti.
Le analisi microbiologiche del latte materno possono essere determinanti nel migliorare la diagnosi di mastite, poiché permettono di identificare gli agenti patogeni e dunque di prescrivere la cura più adeguata.

Possibili complicazione che si possono evitare
Gli studi sul latte materno sono fondamentali per evitare spiacevoli conseguenze.
- Una delle possibili complicazioni in caso di mastite ha a che vedere con l’assunzione di un elevato numero di farmaci. Se l’infezione non viene curata in modo corretto potrebbe avere un effetto indesiderato. Infatti, può succedere che vengano eliminati i batteri che non sono resistenti al trattamento, ma che sono fondamentali per mantenere inalterate le proprietà del latte.
- In assenza di altri batteri, lo stafilococco potrebbe propagarsi e provocare l’ostruzione dei condotti mammari.
- Un’altra possibile complicazione è che l’infezione si ripresenti con frequenza fino a diventare cronica.
- Ci sono casi in cui la mastite provoca candida vaginale.
Le complicazioni della mastite si sono verificate nel 10% dei casi analizzati dagli specialisti, i quali assicurano che si sarebbero potuto evitare con una semplice analisi microbiologica. Indipendentemente dall’acutezza dei sintomi, una diagnosi precoce potrebbe fare la differenza quando a intensità e durata dell’infezione.
Uno studio microbiologico per migliorare la diagnosi di mastite. È questo il progetto realizzato da alcuni specialisti del Dipartimento di nutrizione, bromatologia e tecnologia degli alimenti dell’Universidad Complutense di Madrid.
La mastite è un processo infiammatorio a carico della mammella che colpisce una donna su dieci nelle prime due settimane di allattamento dopo il parto. In genere, questa condizione si cura in maniera efficace con gli antibiotici. Ma può capitare che i batteri si rivelino resistenti ai farmaci.
Il progetto è stato presentato durante l’XI Simposio Internazionale sull’Allattamento al seno e la lattazione. Si pone come obiettivo quello di migliorare la diagnosi della mastite per mezzo di una valutazione delle caratteristiche dei batteri coinvolti in ogni caso. Secondo gli esperti, infatti, le probabilità di successo di ogni cura possono variare se prima si esegue un’analisi microbiologica della malattia.
Perché è utile migliorare la diagnosi di mastite?
Se si estende il periodo di comparsa della malattia oltre le due settimane, i casi di mastite possono arrivare a colpire fino al 95% delle madri che allattano. Ciò significa che la maggior parte delle donne in fase di allattamento potrebbero sviluppare questa infezione prima del primo mese del processo.
In alcuni casi l’infezione potrebbe peggiorare o, non dare alcun segno di risposta positiva alla cura. Ciò avviene perché i batteri sono resistenti agli antibiotici prescritti. Secondo Juan Miguel Rodríguez, il medico che ha condotto la ricerca, i batteri coinvolti nel 50% dei casi di mastite presi in esame, si sono rivelati resistenti alla cura.
Per i casi di mastite è frequente la prescrizione di antibiotici come l’eritromicina e l’amoxicillina. Tuttavia, in oltre la metà dei casi l’organismo non reagisce alle cure come dovrebbe.
Per questo motivi, gli esperti dell’Universidad Complutense di Madrid hanno effettuato questa importante ricerca che consente loro di affermare che la situazione potrebbe migliorare se si eseguisse un antibiogramma e una coltivazione di latte materno.
L’analisi proposta, oltre a migliorare la diagnosi di mastite rendendola molto più specifica, serve a offrire alla paziente una cura più mirata. Per individuare la resistenza di un determinato batterio a un certo gruppo di antibiotici, conviene prima eseguire un antibiogramma.
In questo modo la madre evita l’assunzione di troppi farmaci che a volte può provocare la sospensione dell’allattamento materno, tanto importante invece per il bambino.
Gli effetti dello studio
Secondo gli studi, la mastite è provocata soprattutto da due gruppi di batteri: lo streptococco e lo stafiloccco. Quest’ultimo ha un’incidenza di almeno il 75% dei quattromila casi analizzati dagli esperti del Dipartimento di nutrizione, bromatologia e tecnologia degli alimenti.
Le analisi microbiologiche del latte materno possono essere determinanti nel migliorare la diagnosi di mastite, poiché permettono di identificare gli agenti patogeni e dunque di prescrivere la cura più adeguata.

Possibili complicazione che si possono evitare
Gli studi sul latte materno sono fondamentali per evitare spiacevoli conseguenze.
- Una delle possibili complicazioni in caso di mastite ha a che vedere con l’assunzione di un elevato numero di farmaci. Se l’infezione non viene curata in modo corretto potrebbe avere un effetto indesiderato. Infatti, può succedere che vengano eliminati i batteri che non sono resistenti al trattamento, ma che sono fondamentali per mantenere inalterate le proprietà del latte.
- In assenza di altri batteri, lo stafilococco potrebbe propagarsi e provocare l’ostruzione dei condotti mammari.
- Un’altra possibile complicazione è che l’infezione si ripresenti con frequenza fino a diventare cronica.
- Ci sono casi in cui la mastite provoca candida vaginale.
Le complicazioni della mastite si sono verificate nel 10% dei casi analizzati dagli specialisti, i quali assicurano che si sarebbero potuto evitare con una semplice analisi microbiologica. Indipendentemente dall’acutezza dei sintomi, una diagnosi precoce potrebbe fare la differenza quando a intensità e durata dell’infezione.
Questo testo è fornito solo a scopo informativo e non sostituisce la consultazione con un professionista. In caso di dubbi, consulta il tuo specialista.






